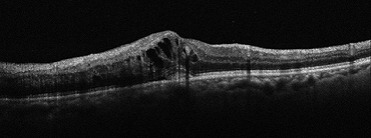

網膜の役割
網膜とは、眼球の裏側(眼底)にある薄い膜のことで、光を感受する役割を持ちます。特に、網膜の中心部には黄斑と呼ばれる色に対する感度の高い視細胞があり、黄斑に何らかの損傷がもたらされると、ぼんやりと色や形が分かるものの、細かな認識が難しくなり、文字が読めなくなるなど日常生活に支障を及ぼします。
黄斑円孔

中心部分が見えづらくなる(中心暗点)や物がゆがんで見えるなどの症状が生じるとされています。
治療としては、現在のところ、点眼薬や内服薬による治療法はなく、手術(硝子体手術)が唯一の治療法となっています。当院では、必要に応じて連携する医療機関をご紹介しております。
加齢黄斑変性

萎縮型は、加齢の影響で黄斑組織が委縮してしまいます。特徴としては、進行がとてもゆっくりで、急激な視力低下をもたらさないということが挙げられます。経過観察が重要になります。
滲出型は、新生血管というもろい血管が生えてきます。血管が破れて出血や、血液中の水分がもれて、黄斑部に浮腫が生じ、障害を起こします。日本人の加齢黄斑変性の患者様の多くはこの滲出型と言われています。症状の進行が早く、著しい視力低下がみられるので、早期診断・早期治療が重要になります。
治療としては、萎縮型の多くは特別な治療を必要とすることはなく、経過観察が重要となります。一方、滲出型は、新生血管を抑制する抗VEGD療法や光凝固術による治療を必要とすることがあります。当院では、必要に応じて連携する医療機関をご紹介しております。
中心性漿液性脈絡網膜症

原因としては、ストレスや副腎ステロイド薬の副作用、妊娠が影響していると考えられています。
中心部がセピア色に見える・暗く感じる、軽度な視力低下、ピントが合わないなどの症状が現れることが多いです。両目に起こることもありますが、片目に起こることもあります。
治療としては、水分(漿液)を排出する作用のある内服薬の服用や、病変の位置によっては、レーザー治療を行います。当院では、必要に応じて連携する医療機関をご紹介しております。
糖尿病網膜症

血糖値の上昇により網膜の毛細血管がダメージを受け、詰まったり出血したりすることで、視力低下を起こします。
糖尿病網膜症は、進行状態により単純糖尿病網膜症、増殖前糖尿病網膜症、増殖糖尿病網膜症と3段階に分けることができ、治療法も異なります。増殖糖尿病網膜症まで進行してしまうと、失明に至る可能性もあり、早期診断と早期治療が重要になります。
まずは血糖値のコントロールが重要になります。そのうえで、増殖前糖尿病網膜症の段階からは新生血管が生じてしまうため、この新生血管の生成や増殖を抑制するために抗VEGF療法や硝子体注射が行われることもあります。当院では、必要に応じて連携する医療機関をご紹介しております。
網膜静脈閉塞症
目のかすみやゆがんで見える、視力低下などが現れます。進行すると、新生血管が作られ、この新生血管から出血が生じ、網膜剥離や硝子体出血を生じることもあります。
治療としては、どこの静脈が閉塞されたかにより異なりますが、血管を拡張させる、あるいは血管壁を強くする薬、浮腫や出血の吸収を促す薬など薬物療法が行われることもあります。また、光凝固術や硝子体注射、硝子体手術が行われることもあります。当院では、必要に応じて連携する医療機関をご紹介しております。





